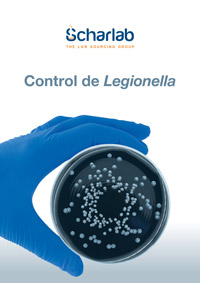
Control Legionella

Control de Legionella: aspectos a considerar para la detección según la ISO 11731:2017
9 de julio de 2025La prevención y el control de la Legionella es un reto prioritario en salud pública, especialmente en instalaciones donde el agua puede convertirse en un vector de transmisión. La correcta aplicación de métodos normalizados y el uso de materiales adecuados son esenciales para garantizar la seguridad y el cumplimiento normativo.
¿Qué es Legionella y por qué es un riesgo?
Legionella es un género de bacterias ambientales de hábitat acuático. Su especie más peligrosa, L. pneumophila, es responsable del 70 % de los casos de legionelosis, una enfermedad que puede manifestarse como una neumonía grave (Enfermedad del Legionario) o una afección leve similar a la gripe (Fiebre de Pontiac).
La bacteria prolifera en instalaciones con agua estancada, temperaturas entre 20–45 °C, biofilms y presencia de nutrientes. Su transmisión ocurre por inhalación de aerosoles contaminados, y no por consumo directo de agua.
Un marco normativo cada vez más exigente
La legislación actual exige controles rigurosos y planes preventivos documentados. Entre las principales referencias normativas se encuentran:
RD 487/2022 y RD 614/2024, que regulan la prevención de la legionelosis en España.
UNE‑ISO 11731:2017, norma internacional de referencia para el recuento de Legionella en agua.
Otras normas como UNE 100030:2023, UNE‑EN 13623:2021 e ISO 19458:2006, que complementan los criterios de calidad, desinfección y muestreo.
Aspectos a tener en cuenta según ISO 11731 para el control de Legionella
La norma ISO 11731 establece los procedimientos de referencia para el análisis microbiológico de Legionella spp.. Las etapas clave incluyen:
1. Toma de muestras
Recipientes estériles con tiosulfato para neutralizar biocidas (≥18 mg/L o 120 mg/L si hay alto cloro).
Medición in situ de pH, temperatura y conductividad.
Transporte refrigerado (5 ± 3 °C) y análisis antes de 24‑48 h.

2. Concentración de la muestra
Filtración con elución (filtros PC o PES, 0,2 µm)
Filtración con colocación directa de la membrana en el medio de cultivo (filtros de celulosa, 0,2–0,45 µm).
Alternativa: centrifugación, si la filtración no es viable.

3. Pre‑tratamiento
Térmico: 50 ± 1 °C durante 30 min.
Ácido: con solución tampón ácida pH 2,2 durante 5 minutos.

4. Medios de cultivo
BCYE: Medio para el cultivo de Legionella estándar.
GVPC, MWY o BCYE + AB: medios selectivos.
BCYE sin cisteína: medio para confirmación.

5. Incubación y lectura
Incubación a 36 ± 2 °C durante 7–10 días en ambiente húmedo.
Realizar examen en el 2º, 3º, 4º, 5º día.
Colonias blancas‑grisáceas, aspecto vítreo y autofluorescentes bajo UV.

6. Confirmación
Resiembra en BCYE y BCYE‑cys.
Identificación con test de látex o inmunofluorescencia.

Productos Scharlab para análisis fiable
En Scharlab ofrecemos una gama completa de productos para realizar el análisis según ISO 11731:
Frascos de muestreo con y sin tiosulfato.
Filtros de membrana (PES, PC o NC).
Medios de cultivo BCYE, GVPC, MWY…
Soluciones tampón y diluyentes.
Cepas de control MiStraCon®Swabs2 con certificación ATCC®.
Equipamiento: incubadoras, baños termostáticos, vortex, cabinas de bioseguridad, estereomicroscopios, etc.
Tabla de decisión: Norma ISO 11731:2017
La elección de un método u otro debe de realizarse siguiendo una matriz de decisiones descritas en el Anexo J de la norma.

 España
España